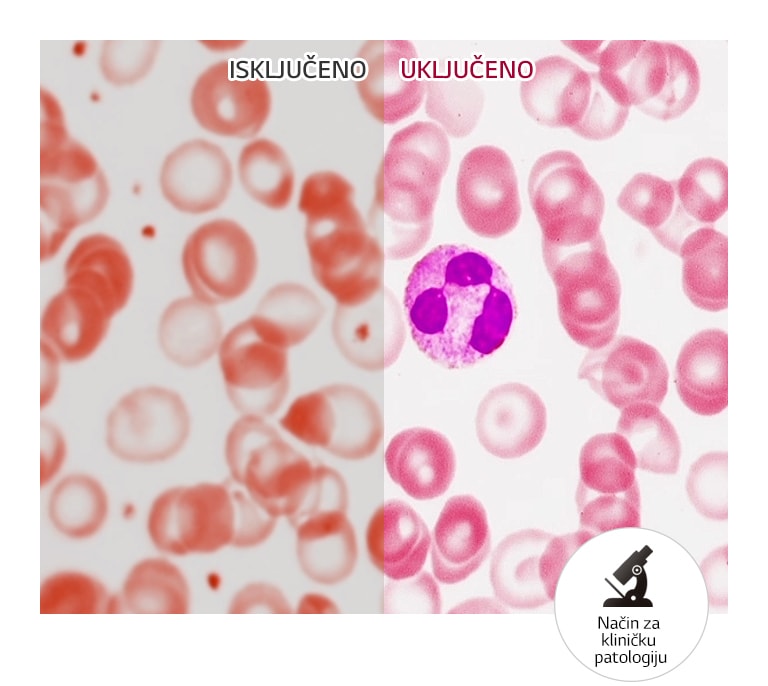
Realistična reprodukcija boja2

DODAJ U POPIS ŽELJA
Dodajte stavke u popis želja MYLG
Prikaz popis želja
32HL512D-M
component-copyModelName
32” 16:9 omjer slike 8MP IPS medicinski monitor
component-OBScountrySelectDesc
*titleText*
component-copyModel-toastMsg
See Retailer for Pricing
Prodaja ograničene količine
Dostupna količina
*quantity* ea
-
Cijena proizvoda(32HL512D-M)
$*rPrice*$*rPromoPrice**discountPDPMsg*Cijena za članove LG-a(32HL512D-M)$*rMemberPrice*$*rMembershipPrice**discountPDPMsg*vip-price-message(32HL512D-M)$*rPrice*$*rVipPrice**discountPDPMsg*OBS_CHEAPERPRICE_MSG $*cheaperPrice*
Cijena za članove LG-a$*rMembershipPrice**rWelcomePriceDescription**rWelcomePriceTooltip*
$*rWelcomePrice*
Ukupno
Preporučena maloprodajna cijena proizvođača
$*improveTotalPrice*
component-previousPrice-prefix
$*rPrice*
$*rPromoPrice*
*discountMsg*
Preporučena maloprodajna cijena proizvođača
$*rPrice*
See Retailer for Pricing
*obsMemberShipLinkStart*
OBS_MEMBERSHIP_MSG $*membershipPrice*
*obsMemberShipLinkEnd*OBS_LOWEST_PRICE_MARK_MSG
OBS_CHEAPERPRICE_MSG $*cheaperPrice*
Preporučena maloprodajna cijena proizvođača
$
See Retailer for Pricing
OBS_MEMBERSHIP_MSG $*recommendedMembershipPrice*
┗ *modelName*
$*discountedPrice*
*userFriendlyName*
bundle-unable-text
$*discountedPrice*
Uštedite $*discountPrice*
component-protectYour
0 component-selectedItems
*modelName*
$*rPrice*.*rPriceCent*
$*rPromoPrice*.*rPromoPriceCent*
*discountMsg*
OBS_LOWEST_PRICE_MARK_MSG
*retailerPricingText*
*modelName*
$*rPrice*.*rPriceCent*
$*rPromoPrice*.*rPromoPriceCent*
*discountMsg*
OBS_LOWEST_PRICE_MARK_MSG
*retailerPricingText*
32” 16:9 omjer slike 8MP IPS medicinski monitor
Preporučena maloprodajna cijena proizvođača
$*rPrice*
Preporučena maloprodajna cijena proizvođača
$*rPromoPrice*
*discountMsg*
Preporučena maloprodajna cijena proizvođača
$
See Retailer for Pricing
Preporučena maloprodajna cijena proizvođača
vip-price-message
$


LG Medical Display
31,5" LG 8MP dijagnostički monitor
Optimizirana kvaliteta slike za
dijagnostičke preglede


31,5" 8MP IPS zaslon
Točna slika iz svakog kuta
31,5-inčni 8MP IPS zaslon pomaže pri preciznoj dijagnozi medicinskih slika. Široki kut gledanja od 178° omogućuje pacijentima i liječnicima da vide točno reproducirane slike uz minimalno izobličenje.


Način višestruke rezolucije
Kompatibilan sa svakim uređajem
Priključivanje na različite vrste uređaja ključna je karakteristika monitora za dijagnostiku. Zahvaljujući načinu višestruke razlučivosti monitora 32HL512D možete prilagoditi razlučivost monitora kako bi ona optimalno odgovarala priključenom uređaju.

Način za kliničku patologiju
Realistična reprodukcija boja
S obzirom na to da monitor LG 32HL512D primjenjuje način za kliničku patologiju s poboljšanom reprodukcijom boja, on može osigurati raskošan prikaz slike s mikroskopa bez izobličenja boja.


Kalibracija automatske osvjetljenosti
Održavana kvaliteta slike
Ugrađena kalibracija automatske osvjetljenosti pomaže pri povećanju produktivnosti i učinkovitosti. Automatski pretvara medicinske slike u slike koje su prikladnije za postavljanje točne dijagnoze.
Za povećanje učinkovitosti i
praktičnosti


PBP i Dvostruki upravljač
Višestruki signali na jednom zaslonu
Značajka PBP (eng. Picture By Picture, „slika do slike”) i dvostruki upravljač služe za upravljanje većim brojem uređaja povezanih s jednim zaslonom s pomoću jedne tipkovnice ili miša i povećavaju praktičnost tijekom pregleda. Možete usporedno pregledavati više informacija na jednom zaslonu.


Ergonomska izvedba
Osmišljeno za postizanje udobnosti i usredotočenosti
Njegovo ergonomsko postolje, podešavanje dvosmjernog okretanja i uski okvir pomažu u ostvarivanju optimalnog radnog prostora za dijagnostiku. Zaokrenite dva monitora u način portreta i upotrebljavajte ih jedan uz drugi kako biste si omogućili vrhunsko iskustvo čitanja.
OPĆE SPECIFIKACIJE
-
- Veličina zaslona
- 31,5"
- Vrsta zaslona
- IPS
-
- Omjer slike
- 16:9
- Razlučivost
- 3840 x 2160
-
- Svjetlina (Typ.)
- typ.: 450 cd/m2
- Omjer kontrasta (original)
- typ.: 1300:1
-
- Vrijeme odziva_tip. (GTG)
- 14ms (Off-setting), 5ms (Faster-setting)
- Kut gledanja (CR≥10)
- 178º(R/L), 178º(U/D)
-
- Raspon boja
- DCI-P3 98%(CIE1976)
ULAZI/IZLAZI
-
- D-Sub
- Ne
- DVI-D
- Ne
-
- HDMI
- Da (1 ea)
- DisplayPort
- Da (2ea)
-
- Thunderbolt
- Ne
- Daisy Chain
- Ne
-
- Izlaz za slušalice
- Ne
- USB Upstream Port
- Da (1 ea/ver2.0)
-
- USB Downstream Port
- Da (2ea/ver3.0)
NAPAJANJE
-
- Vrsta
- Vanjski izvor napajanja (adapter)
- Ulaz
- 100~240V (50/60Hz)
-
- Izlaz
- 19V, 3.42A
- DC napajanje isključeno (Maks.)
- Under 0.3W
POSEBNA ZNAČAJKA
-
- Hot Key
- Ne
- Multi-resolution Mode
- Da (8MP/6MP/4MP)
-
- Bez treperenja zaslona
- Da
- Stabilizator crne
- Da
-
- PIP
- Ne
- PBP
- Da (2PBP)
-
- Dual control
- Da
- HDR
- Da (HDR10)
-
- Način rada za čitanje
- Da
- SUPER + razlučivost
- Da
-
- DICOM Mode
- Da
- OnScreen Control (OSC)
- Ne
-
- Mikrofon
- Ne
- Fotoaparat
- Ne
-
- Smart energy saving
- Da
- HW Umjeravanje
- Da (PerfectLum)
-
- Slabost boje
- Ne
- Automatska svjetlina
- Ne
MEHANIČKI
-
- Odvojiva baza
- Da
- Nagib (kut)
- -5°~20˚
-
- Rotacija (kut)
- Ne
- Visina (raspon)
- 110 mm
-
- Horizontalno okretanje (kut)
- ±90°
Dimenzije
-
- Komplet (s postoljem)
- 718.2 x 590 x 231.2 mm
- Komplet (bez postolja)
- 718.2 x 414.3 x 45.1 mm
-
- Kutija
- 838 x 553 x 240 mm
- Veličina zidnog nosača (mm)
- 100 x 100 mm
-
- Komplet (s postoljem)
- 7 kg
- Komplet (bez postolja)
- 5.6 kg
- Komplet (s postoljem)
-
- Kutija
- 11.4 kg
- Kutija
STANDARDNO
-
- CE
- MDR
- UL (cUL)
- Da
-
- Ostalo
- GMP, MP, RoHS, REACH, WEEE, MFDS
DODATNA OPREMA
-
- Kabel za napajanje
- Da
- D-Sub
- Ne
-
- DVI-D
- Ne
- HDMI
- Da
-
- Display Port
- Da
- Adapter
- Da
- Display Port
-
- USB A to B
- Ne
INFORMACIJE O SUKLADNOSTI
- The safety information for accessories is included with the safety information for the product and is not provided separately.
- Sigurnosne informacije za pribor uključene su uz sigurnosne informacije za proizvod i ne isporučuje se zasebno
- Da biste saznali više o tome kako ovaj proizvod postupa s podacima i o svojim pravima kao korisnik, posjetite „Pokrivenost podataka i specifikacije“ na LG Privacy.
IMATE PITANJA? DOZVOLITE DA VAM POMOGNEMO
Podrška za proizvod
Jednostavno odaberite mogućnost podrške među donjim ikonama:
Za pristup dodatnoj tehničkoj dokumentaciji i preuzimanjima, posjetite LG B2B portal za partnere.
Preporučena maloprodajna cijena proizvođača
$*rPrice*.*rPriceCent*
$*rPromoPrice*.*rPromoPriceCent*
*discountMsg*
*retailerPricingText*
OBS_MEMBERSHIP_MSG $*siblingMembershipPrice*
*obsMemberShipLinkEnd*

















